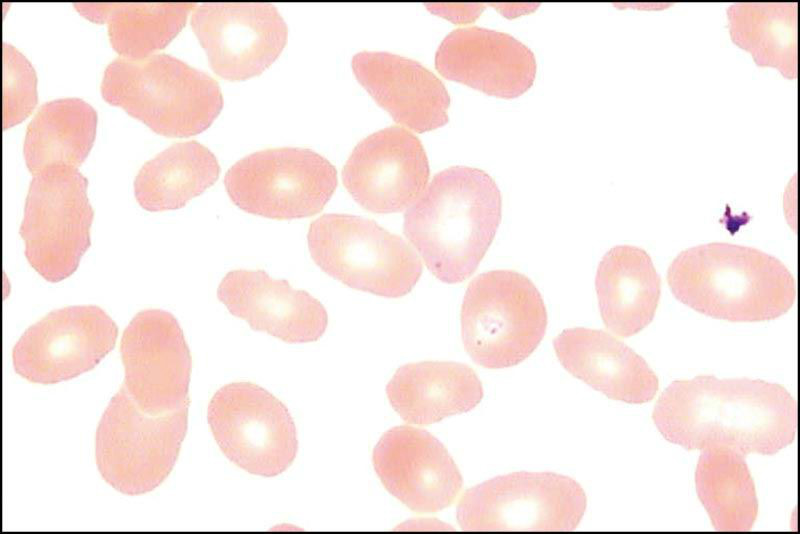
e花环

e花环图

e玫瑰花环
图片尺寸545x409
花环字母e
图片尺寸650x651
e花环实验
图片尺寸489x480
显微镜下的e花环
图片尺寸422x273
ai练习丨花环
图片尺寸3000x2719
医学实验,e-玫瑰花环形成实验 e-玫瑰花环实验 有幸遇见一朵盛开的花
图片尺寸1053x1280
病原实验报告第六弹 e花环 淋巴细胞的正常 过渡型和转化型 小吞噬
图片尺寸2095x1280
医学实验 制作切片观察,活性e-花环
图片尺寸1080x1439
e花环实验报告
图片尺寸482x481
向量几何装饰品.有字母e的断头台花环
图片尺寸1100x1100
e-花环
图片尺寸720x960
lecture4-e花环试验幻灯片.ppt
图片尺寸1152x864
实验三e花环ppt
图片尺寸1080x810
9mn steel after heat treatment at 650 ℃ for 72 h(a
图片尺寸1000x1000
e花环
图片尺寸800x534
法国idee花环项链女 大宝石吊坠项链 韩版时尚挂坠 生日情人节礼物送
图片尺寸350x350
" 这是宇宙中比较常见的一种星系 螺旋星系 这就是自然常数e的定义 e
图片尺寸800x589
实验十一t淋巴细胞玫瑰花结实验ppt
图片尺寸800x600
哈密尔顿图
图片尺寸1080x810
装饰花环
图片尺寸650x620